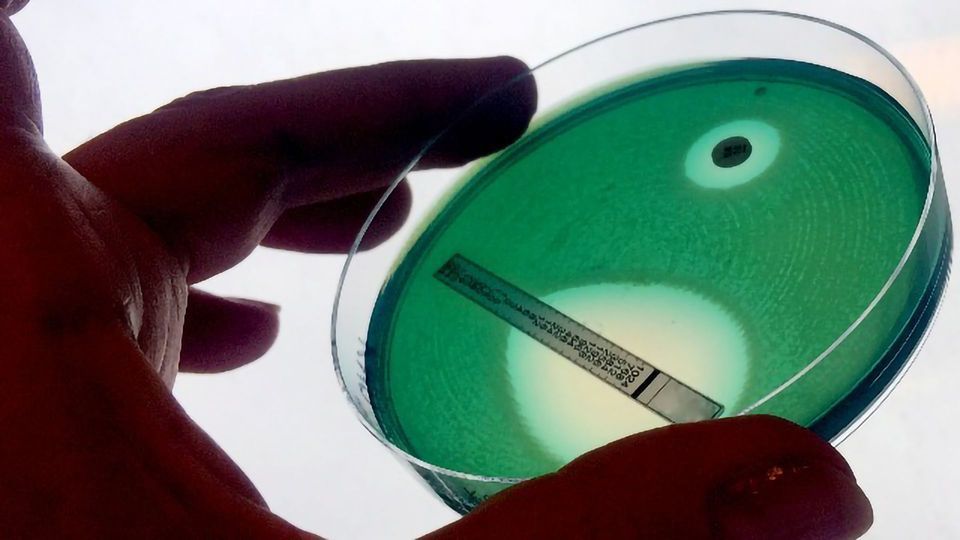
Antimicrobial Resistance: Drivers, Diagnostics and DNA content piece image

Antimicrobial Resistance: Drivers, Diagnostics and DNA
Listicle
Published: April 15, 2019
|
Karen Steward, PhD
,


Senior Scientific Specialist
Karen Steward holds a PhD in molecular microbiology and evolutionary genetics from the University of Cambridge. She moved into science writing in 2017 after over a decade as a research scientist.
Learn about our editorial policies
Michele Trott, PhD
Michele Trott holds a PhD in endocrinology from Lincoln University. She works as a freelance science writer and scientific content manager for Izon Science.
Learn about our editorial policies
&
Molly Campbell


Senior Science Writer
Molly Campbell is a senior science writer at Technology Networks. She holds a first-class honors degree in neuroscience. In 2021 Molly was shortlisted for the Women in Journalism Georgina Henry Award.
Learn about our editorial policies
Credit: iStock.
Antimicrobial resistance (AMR) is a huge global problem, leading to thousands of deaths each year and threatening our ability to treat an ever-increasing range of infections.
Combating AMR is going to take coordinated action of different approaches, such as improved public education and national action plans, greater surveillance, improved diagnostics, and the ability to harness advances in genomics and big data.
Download this list to learn about:
- Factors driving the spread of AMR
- The part diagnostics has to play in combating AMR
- How genomics and machine learning could provide helpful insights
Meet the Authors

Senior Scientific Specialist
Karen Steward holds a PhD in molecular microbiology and evolutionary genetics from the University of Cambridge. She moved into science writing in 2017 after over a decade as a research scientist.

Michele Trott holds a PhD in endocrinology from Lincoln University. She works as a freelance science writer and scientific content manager for Izon Science.

Senior Science Writer
Molly Campbell is a senior science writer at Technology Networks. She holds a first-class honors degree in neuroscience. In 2021 Molly was shortlisted for the Women in Journalism Georgina Henry Award.
Advertisement




